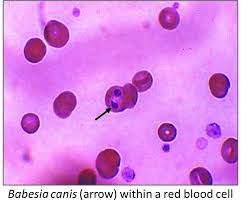
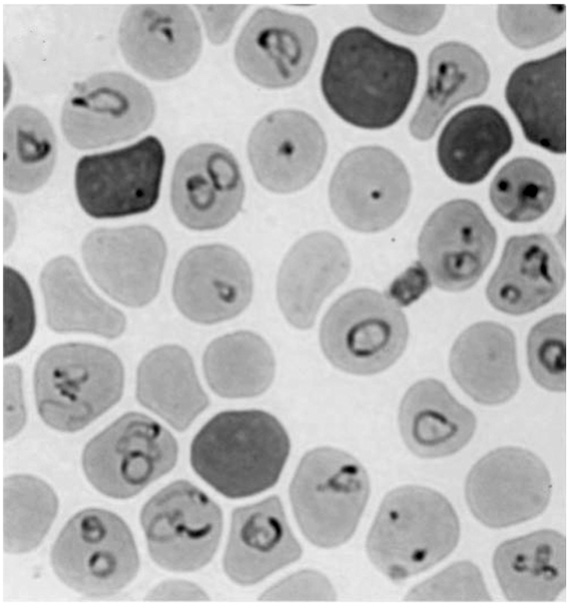

Introduction


Babesia is a malaria-like organism that infects red blood cells. When you read things like this then go research what malaria is so that you can have a better understanding of the disease. Remedies that treat malaria can often be used for malaria-like organisms as well. Babesia is a parasite and it must infect anything with red blood cells to survive.
Babesia infected red blood cells. Remember, Babesia infects the blood.

This really shows what a blood infection looks like.
Scientists believe Babesia microti is the most common version infecting humans but they have identified over twenty different versions carried by ticks. It is most commonly carried by the white footed mouse. It does not cause disease to the mouse or the ticks that carry it. In addition to transmission by a tick, Babesia can be transmitted through contaminated blood transfusion and even from mother to unborn child.
Are US blood donors being tested for Babesiosis? No.
Blood banks do not screen donated blood for Babesia.


Babesia parasites have a pretty complex life cycle. It goes through many stages and actually changes shape a couple times as it gets passed between the Ixodes tick and other warm red blooded mammals. Over 100 different Babesia have since been identified but we only know a couple that infect humans.

You typical life cycle of Babesia courtesy of the CDC.
We have known for a long time that horses, cows, and dogs get Babesia infections. Goats and pigs sometimes get it too. Apparently it crossed over to infecting humans in 1957 when a young Croatian farmer contracted it and was dead a couple days later of kidney failure. Babesia caused so many red blood cells to rupture at the same time that it overwhelmed the filtering of his kidneys and they failed. In 1969 the disease had made it’s way to the United States. It started in Nantucket Island and now it’s pretty much everywhere. New York state has increased 20x in 10 years.

Babesiosis has been reported in North and South America, Europe, and southern and eastern Asia. In the United States Babesia microti is usually transmitted by the bite of Ixodes tick, the same tick species that carries Lyme disease Borrellia. B. microti mainly live in the northeast. occur in the eastern half of the United States. southern New England and the northern Midwest. Different babesia species are found in the western United States. Cases from Missouri and Kentucky have also been reported.Very few laboratories have the ability to truly test for Babesia. False positives are common. You don’t think you have the disease because they didn’t find it. The reality is many people have it and don’t know it.


The first Babesia species was discovered in 1888 by Victor Babes, a Hungarian pathologist that it was named after. The first case of Babesiosis was reported from Nantucket Island, Massachusetts, in 1969. Since the late 1980’s the disease has spread across the United States, Europe, and Asia. Babesiosis infection has likely been worldwide the whole time. We really know very little about it other than it is “malaria like”.

Scanning electron microscope picture showing Babesia and red blood cells
A wide range of Babesia infections inside the critical red blood cell–the cell carrying oxygen to all of the body’s cells. It is highly unusual to see this many infected cells at once. Babesia is hard to diagnose. What is routine is to examine a blood sample for three minutes as the CDC suggests and see no infected cells.

It takes a rare and exceptional lab staff to recognize Babesia on a slide.
Symptoms
The beginning symptoms o fa Babesia infection are similar to those of Lyme disease but Babesiosis more often starts with a high fever and chills. As the infection progresses people get weak and can have a shortness of breath known as “air hunger”. People feel the need to immediately take a deep breath. Headache, drenching sweats, muscle aches, chest pain, and hip pain occurs. Ironically in some Babesiosis can often be so mild it is not noticed but in others it can be life-threatening. This is especially true with people with no spleen, the elderly, and people with weak immune systems. The spleen helps to filter and recycle blood. When people are missing one they cannot handle the massive die off of red blood cells cause by babesiosis. Sometimes complications can be very severe including very low blood pressure, liver problems, severe anemia (a breakdown of red blood cells), kidney (organ) failure, and even death.

Air hunger is a condition when people feel the need to suddenly gasp for air. Sometimes they are having labored breathing trouble and it feels like enough air just isn’t getting into the lungs. It causes a bit of a panic! With air hunger you’ll feel the need to breathe deep but it will be difficult when you try. The unfortunate person is left with an ongoing and distressing feeling of not being able to get enough air.

Air hunger…
Babesia can hide from our immune system. Some of the infections of Lyme Disease can change their physical shape to evade the immune system. Babesia is one of these shape shifters. It can rearrange it’s outside to hide from the immune system when it comes around. This is classic for Lyme disease.
It can exist in a chronic asymptomatic state for years or decades just waiting on conditions to become favorable for it to express itself again. One example is chronic stress causing the body to become acidic. Babesia loves an acidic body. Babesia can then suppress the immune system while it’s already down. Babesia makles it harder for the body to get rid of other parasitic infections. It makes the body hold onto them. It increases symptoms.
Standard treatment regimens do not work well with Babesia. In severe cases, blood exchange transfusions have been performed to lower the parasitic load in the individual. We need new creative ways to attack this problem. Anti-malaria drugs only help for a little while before it builds resistance. Ozone kills it.
Diagnosis of Babesia – a false sense of security.
Babesiosis is one of the most deadly tick infections on earth. It is not rare, a mere “co-infection, or “occasionally” present. It is a serious problem all by itself. It should always be checked in anyone if they’ve had a tick bite, they think they might have Lyme, or if they’ve ever had a blood transfusion. I recommend having it tested and restested., Have it directly and indirectly tested if you suspect it. Almost all direct testing is 95% inaccurate with the exception of IGeneX, which is only 75% inaccurate. IGeneX detects Babesia approximately 25% of the time if you perform full testing of Babesia microti and Babesia duncani antibodies, PCRs and a FISH test. Sadly this still means they miss it 75% of the time. That’s what is meant by false negatives.
Sometimes Babesia can be detected in blood examined under a microscope. However, this method is reliable only in the first couple weeks of the infection. They have to visually see the parasite in the blood cell to diagnose it this way. This is only one way to diagnose Babesia. It is not easy. Once Babesia gets inside a red blood cell it rapidly divides and takes over the cell.

Babesia stained purple within red blood cells.

This shows Babesia infecting a red blood cell and taking it over.
Once the cells are overflowing with Babesia they spontaneous rupture. The red blood cells are destroyed. They clog up the kidneys and spleen. The liver must process all of the new infection. The blood is full of junk now. The immune system is going haywire. The lumph system now has to flush out even more. New Babesia can then spread throughout the body. They go on to infect more red blood cells again and the cycle repeats every several months with a relapse of symptoms. The person keeps getting flu like symptoms. Their joints keep hurting. Maybe it’s the wandering arthritis but that doesn’t explain the fever. The destruction of red blood cells and small blood vessels can cause bruising and formation of petechiae (small red spots on the skin).

This is not a cherry on an ice cream cone. It’s a little gift from Babesia caused by the destruction of the blood.




Commercial tests currently detect only two of the numerous strains of Babesia and there are likely many strains yet to be discovered.
You can have false negative testing. IGeneX has a test that helps visualize Babesia duncani and microti.


The PCR (polymerase chain reaction) test can detect Babesia DNA in the blood. The FISH (Fluorescent In-Situ Hybridization) assay can detect the RNA of Babesia in thin blood smears. Labs can also test the patient’s blood for antibodies to Babesia. It may be necessary to run several different tests. A single negative test does not necessairily rule out infection. Positives don’t lie and negative results aren’t very reliable. Once again, it has been reported that direct testing for Babesia is 95% inaccurate.

The FISH image, in black and white, enhances the visibility of Babesia microti and duncani.
Babesiosis is typically treated with a combination of anti-malarial drugs and antibiotics. Relapses sometimes occur after treatment and must be retreated. Babesia is becoming increasingly resistant to antimocrobial medications. Doxycycline is commonly used for tick-borne infections but is not effective against babesia.
11 Facts About Babesiosis – a quick rehash.
1. “Babesiosis” refers to the disease itself; “Babesia” refers to the parasite that causes the disease. Someone who has babesiosis may be said to have a “babesia infection.”
2. Babesia is thought to be the second most common blood parasite in mammals. (And the winner in that race? Trypanosomes, which causes sleeping sickness.
3. Babesia organisms are found much more frequently in animals than humans. They did not start infecting humans until recently. The number of reported human infections is rising. I wonder if the number is actually going up, or it’s always been high and we’re just testing more for it. The more you test the more you find, know what I mean?
4. How is babesia spread to humans? Typically through a tick bite. (Move over Lyme Disease; the Bab is right behind you! ) Ticks often carry more than 1 parasitic infection. One recent study showed that 71% of infected ticks only carried 1 organism. 30% of ticks had 2 infections, and 5% had 3 or more infectious organisms.
5. One good but of news is that most cases are actually mild and so some people don’t even know they’ve been infected. The bad news is that makes it easier to pass on through blood donation.
6. Ah, but what about blood testing, you ask? Do they screen donors for this blood disorder? Surely the donors should be told they have infected blood, you say.. As of this date, 6-24-17, there is no FDA-approved test that screens for babesia in the blood.
7. When people have symptoms most will only have a mild fever and a mild anemia. But severe cases will present in a manner similar to malaria and can lead to multi-organ failure and death.
8. Those most at risk of developing a severe form when infected include those without spleens, those with a weakened immune system, and the elderly.
9. Victor Babes is the lucky bacteriologist after whom babesia and babesiosis are named.
10. Promptly and carefully removing any ticks safely as soon as possible can go a long way toward preventing babesiosis. Get a set of tweezers and pull the tick with steady even pressure.
11. Babesia has been said to be the most common Lyme co-infection. It has been found in 66% of Lyme cases in some areas.
.